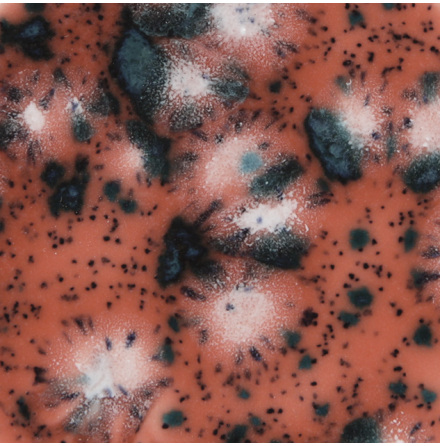
Coral Puff

Landväljare
Svenska
SEK
Sök
Mayco
Mayco är en tillverkare från USA av glasyrer för stengods och lergods och diverse tillbehör för keramik. De tillverkar även skröjbrända gjutna keramiska föremål så kallade bisque, färdiga att dekorera med glasyr och bränna.
Inspiration på glasyrkombinationer.
Mer information:
från 61 SEK
I lager
Artnr. UG227
61 SEK
I lager
Artnr. DSS163
354 SEK
I lager
Artnr. EL-121
244 SEK
I lager
Artnr. SW-129
225 SEK
I lager
Artnr. SW-130
259 SEK
från 135 SEK
I lager
Artnr. RK101
246 SEK
I lager
Artnr. SW-133
288 SEK
I lager
Artnr. RK105
246 SEK
I lager
Artnr. SW-304
75 SEK
I lager
Artnr. SD-205
1.694 SEK
I lager
Artnr. SW-512
259 SEK
I lager
Artnr. SW-205
288 SEK
I lager
Artnr. CG-980
319 SEK
I lager
Artnr. SW-168
259 SEK
I lager
Artnr. SW-128
259 SEK
I lager
Artnr. FN-031
241 SEK
I lager
Artnr. S-2718
319 SEK
från 60 SEK
I lager
Artnr. SP216
331 SEK
I lager
Artnr. SC25
151 SEK
från 61 SEK
I lager
Artnr. FN-208
241 SEK
I lager
Artnr. S2kit
1.111 SEK
från 60 SEK
från 60 SEK
I lager
Artnr. MB-1372
545 SEK
I lager
Artnr. MB-1386
405 SEK
I lager
Artnr. MB-1371
555 SEK
I lager
Artnr. EL-144
244 SEK
Ej i lager
Artnr. FN-019
241 SEK
från 135 SEK
I lager
Artnr. DSS114
354 SEK
I lager
Artnr. SW-509
259 SEK
från 61 SEK